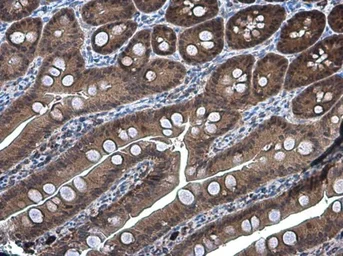
Anti-DARPP-32 antibody used in IHC (Paraffin sections) (IHC-P). GTX133350

DARPP-32抗体
目录号 GTX133350
目录号 GTX133350
-
宿主Rabbit
-
克隆Polyclonal
-
同种型IgG
-
实验应用WB ICC/IF IHC-P IHC-Fr
-
种属反应Mouse, Rat